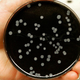
Nam ob rahljanju ukrepov grozi še ena pljučnica?

V okolici mesta Rzeszow na jugovzhodu Poljske je prišlo do izbruha legionarske bolezni. Doslej je zaradi bolezni umrlo najmanj 14 ljudi, potrjenih pa je bilo več kot 150 primerov. Oblasti … · Regional · 2L
rzeszow poljska legionarska bolezen objavi tvitaj

Evropski center za preprečevanje in obvladovanje bolezni (ECDC) je ta teden objavil, da se je v Evropski uniji v letu 2021 močno povečala pojavnost legioneloze. Zabeležili so preko deset tisoč … · Aktivni.si · 2L

V Argentini so skrivnostne smrti zaradi pljučnice v zadnjih dneh, ki so begale pristojne, vendarle povezali z legionarsko boleznijo. Ta razmeroma redka bakterijska okužba pljuč je bila vzrok smrti štirih … · Svet24 · 3L
pljučnica legionarska bolezen argentina pojasnilo objavi tvitaj
Ob sproščanju številnih ukrepov se bodo kmalu na novo odprle številne stavbe, ki že tedne samevajo – šole, vrtci, restavracije, podjetja, hoteli ipd. Vse stavbe, ki so bile zaradi preprečevanja … · Siol.net · 5L
okužba koronavirus legionela covid-19 pljučnica objavi tvitaj

Primarij Darija Strah, dr. med. specialistka ginekologije in porodništva Koronavirusi povzročajo bolezni pri ljudeh in živalih. Konec leta 2019 se je na Kitajskem v mestu Wuhan pojavila nova okužba s … · Žurnal24 · 5L
koronavius janez tomažič covid 19 mateja logar objavi tvitaj